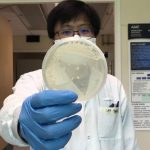

New gene regulation model provides insight into...
In every cell, RNA-binding proteins (RBPs) help tune gene expression and control biological processes by binding to RNA sequences. Researchers often assume that individual RBPs latch tightly to just one RNA sequence. For instance, an essential family of RBPs, the Rbfox family, was thought to bind one particular RNA sequence alone. However, it’s becoming increasingly clear that this idea greatly oversimplifies Rbfox’s vital role in development. Members of the Rbfox family are among the best-studied RBPs and have been...